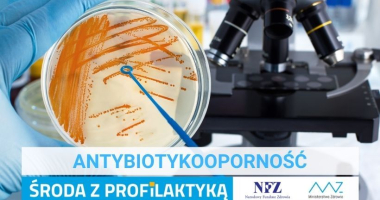

Porady

Baw sie dobrze! #NIEspieczRAKA
19.05.2022

Gotowi oddać krew - baza danych
14.03.2022
Oporność na antybiotyki
17.02.2022

Mężczyzno, zadbaj o swoje zdrowie!
03.11.2021

Groźny udar mózgu
27.10.2021

Otyłość szkodzi zdrowiu
20.10.2021

W kryzysie psychicznym nie jesteś sam. Sprawdź, gdzie znaleźć pomoc
11.10.2021

Depresja - choroba, którą należy leczyć
06.10.2021

Zadbaj o serce
29.09.2021
Copyright © 2023 Powiat Olsztyński. All rights reserved. Realizacja: Internet Arts

